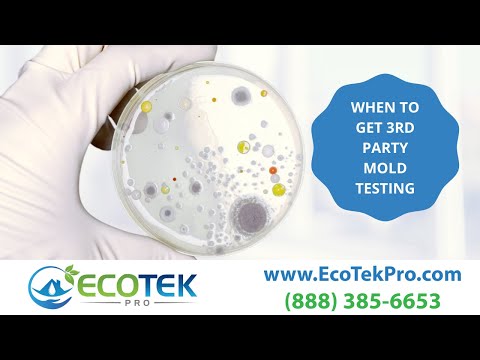

EcoTek Pro
Are Mold Remediation Prices Too High, Too Low or Just Right?
5:48

EcoTek Pro
Does Homeowners Insurance Cover Water Damage | Tips to Make Sure You Have Enough Insurance Coverage
7:20

EcoTek Pro
How To Deal With Water Damage In Your Home
6:25

EcoTek Pro
Hurricane Preparedness Tips 2021| What To Do To Protect Your Property If A Hurricane Comes
7:44

EcoTek Pro
Is Mold Remediation Covered by Homeowners Insurance | Tips on How To File the Claim
9:35

EcoTek Pro
Mold Testing & Assessment Tools | Indoor air quality & Mold Inspection
10:14

EcoTek Pro
How Much does Mold Remediation Cost?
6:42
![When is Mold Remediation Necessary? [2021]](/vi/PIe5srECCis/hqdefault.jpg?sqp=-oaymwEjCNACELwBSFryq4qpAxUIARUAAAAAGAElAADIQj0AgKJDeAE=&rs=AOn4CLArKicihkzJSYDCEg3f_hOF7glvzg)
EcoTek Pro
When is Mold Remediation Necessary? [2021]
6:43

EcoTek Pro
Who Does Mold Remediation? | Who To Hire For Mold Removal
6:04

EcoTek Pro
What Is Mold Remediation? | Mold Removal vs. Mold Abatement vs Mold Mitigation
9:13
![How to Protect Valuables From Fire [2020]](/vi/b6bSyHcQ6Ik/hqdefault.jpg?sqp=-oaymwEjCNACELwBSFryq4qpAxUIARUAAAAAGAElAADIQj0AgKJDeAE=&rs=AOn4CLBv1th_IFnCWlidp1gyuSZhN7_XAQ)
EcoTek Pro
How to Protect Valuables From Fire [2020]
13:43

EcoTek Pro
Home Buying | Things to Know That Could Save You Thousands
18:26

EcoTek Pro
Hoarding
8:37

EcoTek Pro
Can any contractor remove mold?
9:31

EcoTek Pro
Did your mold protocol include cleaning your ac?
6:20

EcoTek Pro
Black Mold Scare Tactics
8:26
EcoTek Pro
3rd Party Mold Testing
6:52

EcoTek Pro
Should You Turn Your AC Up When You Leave For Vacation?
7:16

EcoTek Pro
When To Hire Public Adjusters
10:19

EcoTek Pro
Allergies in the office: Moldy Office Making You Sick
3:09

EcoTek Pro
Dryout Vs Cutout. Your Dryout Company Might Not Be Telling You Everything
3:23

EcoTek Pro
Water Damaged Apartment Unit Causes Massive Mold Growth | Mold Remediation
5:09

EcoTek Pro
Mold In Shower and Bathroom | Tips On How to Prevent Mold In Bathroom
6:20

EcoTek Pro
Water and Mold Damage | 10 Damaged Area In a Single Home
15:18

EcoTek Pro
EcoTek Pro: Mold Remediation Process Before & After | Kitchen & Bathroom Remodel | Boca Raton Fl
1:14:02

EcoTek Pro
Mold Remediation Estimates From West Palm Beach To Miami
5:42

EcoTek Pro
Should I get UV lights to kill AC Mold? UV lights vs PCO Air Purification Devices.
8:43

EcoTek Pro
Does Bleach Kill Mold? Tips on How to Kill Mold
14:30

